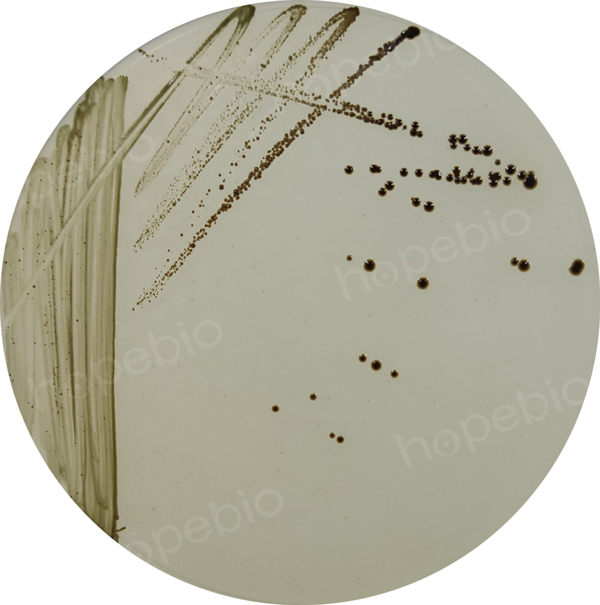

海博微信公众号
海博微信公众号
 海博天猫旗舰店
海博天猫旗舰店


 海博微信公众号
海博微信公众号
 海博天猫旗舰店
海博天猫旗舰店




一、柠檬酸杆菌简介
柠檬酸杆菌(Citrobacter),革兰氏阴性兼性厌氧菌。直杆菌、直径约1.0μm,长2.0μm~6.0μm。有呼吸和发酵两种代谢类型。氧化酶阴性,动力试验、ONPG试验阳性,能利用柠檬酸盐,能够液化明胶,DNA酶试验和V-P试验阴性。根据《伯杰氏细菌学分类手册》,柠檬酸杆菌属分为弗氏柠檬酸杆菌(C.freundii)、科氏柠檬酸杆菌(C.diversus)和无丙二酸盐柠檬酸杆菌(C.amalonaticus)三个种。
二、参考标准;
《SN/T 2552.6-2010 乳与乳制品卫生微生物学检验方法 第6部分:柠檬酸杆菌检验》
三、检测步骤及结果判断
3.1 增菌
无菌称取样品100g,10g和1g各三份分别加入2000mL、250mL和100mL样品稀释瓶中,加入9倍预热到45℃的灭菌蒸馏水(1:10稀释),或者将样品直接称量到装有9倍预热到45℃的灭菌蒸馏水的样品稀释瓶中,振摇使样品充分混匀,36℃±1℃培养18h~24h。
分别移取培养18h~24h的悬液各10mL加入90mL四硫磺酸盐煌绿增菌肉汤(TTB)中,36℃±1℃培养18h~24h。
四硫磺酸盐煌绿增菌肉汤(TTB)检验原理:
蛋白胨和牛肉粉提供碳源、氮源和维生素,满足细菌生长的需求;氯化钠可维持均衡的渗透压;碳酸钙能中和细菌产酸及吸收有毒的代谢产物;硫代硫酸钠和四硫磺酸钠结合可抑制肠道共生菌(四硫磺酸钠是在培养基加入碘和碘化钾时形成),而具有四硫磺酸钠还原酶的细菌能在此培养基中繁殖;胆盐和煌绿可抑制大肠群菌和其它革兰氏阳性细菌。
四硫磺酸盐煌绿增菌肉汤(TTB)用法:
称取本品93.55g,溶解于1050mL蒸馏水中,加热煮沸,121℃高压灭菌15分钟,临用前加入20%碘液 20mL,0.1% 煌绿10mL,现配现用,不宜久置。培养结果如图1所示:

图1 弗氏柠檬酸杆菌在TTB中的培养结果
3.2 分离培养
轻轻混匀增菌液,每份增菌液用接种环接种沙门氏菌志贺氏菌分离琼脂(SS)平板、亚硫酸铋琼脂(BS)平板。采用三区法或四区法划线,以获得单个菌落。将平板倒置于36℃±1℃,SS琼脂平板培养18h~24h,BS琼脂平板培养40h~48h。
从SS平板和BS平板上分别挑取3个~5个可疑菌落,在营养琼脂斜面上纯化培养。柠檬酸杆菌在SS琼脂平板上的可疑菌落为圆形,粉红色、黑色、无色菌落,或粉红色、黑色中心菌落;在BS琼脂平板上的可疑菌落为棕绿色或棕黑色菌落。
SS琼脂培养基检验原理:
䏡胨、牛肉浸粉提供碳源、氮源、维生素和矿物质;乳糖为可发酵的糖类;三号胆盐、枸橼酸钠和煌绿抑制革兰氏阳性菌及大多数的大肠菌群和变形杆菌;硫代硫酸钠和枸橼酸铁用于检测硫化氢的产生,使菌落中心呈黑色;中性红为pH指示剂,发酵糖产酸的菌落呈红色,不发酵糖的菌落为无色;琼脂是培养基的凝固剂。
SS琼脂培养基用法:
称取本品63.53g,溶解于1000mL蒸馏水中,加热煮至沸,不必高压蒸汽灭菌,冷至45℃-50℃倒成平板。培养结果如图2所示:

图2 弗氏柠檬酸杆菌ATCC 43864在SS琼脂平板上的培养结果
亚硫酸铋琼脂(BS)检验原理:
蛋白胨、牛肉粉在培养基中作为基础营养物质,为细菌生长提供所需的氮源、碳源、维生素及一些矿物质等元素;葡萄糖可作为细菌生长代谢所需的能量物质;磷酸盐对培养环境pH值起到缓冲作用。煌绿和亚硫酸钠能抑制大肠杆菌、变形杆菌和革兰氏阳性菌的生长。伤寒沙门氏菌及其他沙门氏菌能利用葡萄糖,将亚硫酸盐还原成硫化物并与硫酸亚铁反应使得菌落呈黑色,此外还可把铋离子还原成金属铋,使菌落呈现金属光泽,从而使沙门氏菌得到分离。
亚硫酸铋琼脂(BS)用法:
称取本品50.3g,加入1000 mL蒸馏水中,加热煮沸至完全溶解,冷至45℃-50℃,摇匀,倾入无菌平皿备用。无需高压灭菌。保存于黑暗处,48小时内使用。培养结果如图3所示:
图3 弗氏柠檬酸杆菌ATCC 43864在BS琼脂平板上的培养结果
3.3 分离鉴定
3.3.1 方法选择
对挑选的菌体进行革兰氏染色,氧化酶试验初步生化鉴定。革兰氏染色阴性,氧化酶试验阴性按3.3.2进行初步生化试验。革兰氏染色结果如图4A,氧化酶试验结果如图4B:

图4 弗氏柠檬酸杆菌ATCC 43864革兰氏染色结果,弗氏柠檬酸杆菌ATCC 43864氧化酶实验结果
3.3.2 初步生化鉴定
使用营养琼脂平板或斜面上纯化分离的新鲜培养物(培养时间不超过24h)进行动力试验、ONPG试验、柠檬酸盐试验、DNA酶试验(或明胶液化试验)和V-P试验。动力试验、ONPG试验和柠檬酸盐试验阳性,DNA酶试验(或明胶液化试验)和V-P试验阴性的菌落为柠檬酸杆菌属细菌。再次用营养琼脂纯化培养18h~24h后,进行后续生化试验。初步生化鉴定结果如图5所示:

图5 弗氏柠檬酸杆菌ATCC 43864初步生化鉴定结果
3.3.3 生化鉴定
使用营养琼脂上的新鲜培养物(培养时间不超过24 h)按表1各项生化试验进行柠檬酸杆菌各种的鉴定。确证鉴定结果如图6所示:
表1 柠檬酸杆菌属生化鉴定表
|
确证实验 |
弗氏柠檬 酸杆菌 (C.freundii) |
科氏柠檬 酸杆菌 (C.diversus) |
无丙二酸盐 柠檬酸杆菌 (C.amalonaticus) |
|
水杨酸发酵产酸 |
﹣ |
V(﹣) |
V |
|
D-戊糖醇发酵产酸 |
﹣ |
+ |
﹣ |
|
产硫化氢 |
V(+) |
﹣ |
﹣ |
|
鸟氨酸脱酸酶 |
V(﹣) |
+ |
+ |
|
靛基质 |
﹣ |
+ |
+ |
|
丙二酸盐利用 |
V(﹣) |
+ |
﹣ |
|
注:+:≥90%阳性;(+):75%~89%阳性;d:不同菌株不定;(﹣):75%~89%阴性;﹣:≥90%阴性。 |
|||

图6 弗氏柠檬酸杆菌确证生化鉴定结果
四、结果判定与结果报告
4.1 结果判定
4.1.1 柠檬酸杆菌属
革兰氏染色阴性,氧化酶实验阴性,生化反应符合3.3.2要求的菌落,判定为柠檬酸杆菌属细菌。
4.1.2 柠檬酸杆菌
革兰氏染色阴性,氧化酶实验阴性,生化反应结果与3.3.2和3.3.3中表1的生化反应结果相符,或根据生化鉴定试剂盒、生化鉴定系统鉴定到柠檬酸杆菌属的结果,可判定为特定的柠檬酸杆菌。
4.2 结果报告
生化鉴定结果符合柠檬酸杆菌生化特性,按增菌培养的阳性瓶数,应用MPN表,查出每100 g样品中的MPN值。检测结果报告为每100 g样品中柠檬酸杆菌(属或种)的MPN值。
表2 最可能数(MPN)表(95%置信区间)
使用三管法,接种量分别为10.0 g,1.0 g和0.1 g。
|
阳性管数 |
MPN /100g |
可信限 |
阳性管数 |
MPN /100g |
可信限 |
||||||
|
10 |
1 |
0.1 |
低 |
高 |
10 |
1 |
0.1 |
低 |
高 |
||
|
0 |
0 |
0 |
<3.0 |
- |
9.5 |
2 |
2 |
0 |
21 |
4.5 |
42 |
|
0 |
0 |
1 |
3.0 |
0.15 |
9.6 |
2 |
2 |
1 |
28 |
8.7 |
94 |
|
0 |
1 |
0 |
3.0 |
0.15 |
11 |
2 |
2 |
2 |
35 |
8.7 |
94 |
|
0 |
1 |
1 |
6.1 |
1.2 |
18 |
2 |
3 |
0 |
29 |
8.7 |
94 |
|
0 |
2 |
0 |
6.2 |
1.2 |
18 |
2 |
3 |
1 |
36 |
8.7 |
94 |
|
0 |
3 |
0 |
9.4 |
3.6 |
38 |
3 |
0 |
0 |
23 |
4.6 |
94 |
|
1 |
0 |
0 |
3.6 |
0.17 |
18 |
3 |
0 |
1 |
38 |
8.7 |
110 |
|
1 |
0 |
1 |
7.2 |
1.3 |
18 |
3 |
0 |
2 |
64 |
17 |
180 |
|
1 |
0 |
2 |
11 |
3.6 |
38 |
3 |
1 |
0 |
43 |
9 |
180 |
|
1 |
1 |
0 |
7.4 |
1.3 |
20 |
3 |
1 |
1 |
75 |
17 |
200 |
|
1 |
1 |
1 |
11 |
3.6 |
38 |
3 |
1 |
2 |
120 |
37 |
420 |
|
1 |
2 |
0 |
11 |
3.6 |
42 |
3 |
1 |
3 |
160 |
40 |
420 |
|
1 |
2 |
1 |
15 |
4.5 |
42 |
3 |
2 |
0 |
93 |
18 |
420 |
|
1 |
3 |
0 |
16 |
4.5 |
42 |
3 |
2 |
1 |
150 |
37 |
420 |
|
2 |
0 |
0 |
9.2 |
4.4 |
38 |
3 |
2 |
2 |
210 |
40 |
430 |
|
2 |
0 |
1 |
14 |
3.6 |
42 |
3 |
2 |
3 |
290 |
90 |
1000 |
|
2 |
0 |
2 |
20 |
4.5 |
42 |
3 |
3 |
0 |
240 |
42 |
1000 |
|
2 |
1 |
0 |
15 |
3.7 |
42 |
3 |
3 |
1 |
460 |
90 |
2000 |
|
2 |
1 |
1 |
20 |
4.5 |
42 |
3 |
3 |
2 |
1100 |
180 |
4100 |
|
2 |
1 |
2 |
27 |
8.7 |
91 |
3 |
3 |
3 |
>1100 |
420 |
- |
|
注:如果接种量扩大10倍,分别为100.0g,10.0g和1g时,表中的数字相应缩小10倍。如果接种量缩小10倍,分别为1.0g,0.1g和0.01g时,表中的数字相应扩大10倍,其余类推。 |
|||||||||||
相关标准:
SN/T 2552.6-2010 乳与乳制品卫生微生物学检验方法 第6部分:柠檬酸杆菌检验 点击下载
相关产品:
注:本文属海博生物原创,未经允许不得转载。
上一篇:蜡样芽孢杆菌检验方法及结果判断
下一篇:阴沟肠杆菌的检验方法及结果判断



